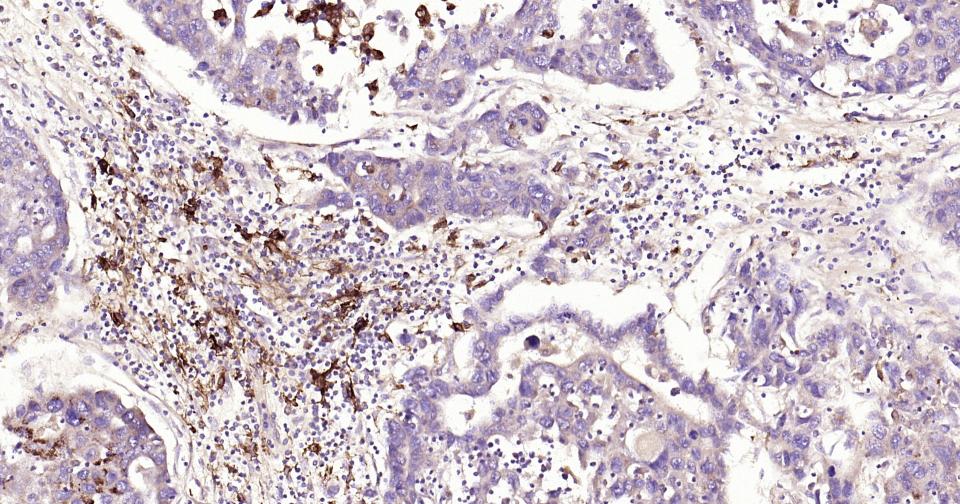
基质金属蛋白酶-9重组兔单抗

Cancer > Invasion/microenvironment > Angiogenesis > ECM enzymes > MMPs
Cancer > Invasion/microenvironment > ECM > Extracellular matrix > MMPs
Cancer > Tumor biomarkers > Enzymes > MMPs
Cardiovascular > Angiogenesis > Adhesion / ECM > Matrix Metalloproteinases > MMP
Cardiovascular > Atherosclerosis > Thrombosis
Cell Biology > Proteolysis / Ubiquitin > Proteolytic enzymes > Metalloprotease > MMPs
Kits/ Lysates/ Other > Kits > ELISA Kits > ELISA Kits > Atherosclerotic proteins ELISA kits
Kits/ Lysates/ Other > Kits > ELISA Kits > ELISA Kits > Cancer proteins ELISA kits
Kits/ Lysates/ Other > Kits > ELISA Kits > ELISA Kits > Protease inhibitors ELISA kits
Signal Transduction > Cytoskeleton / ECM > Extracellular Matrix > ECM Enzymes > MMP
bs-7059P is one synthetic peptide derived from human MMP-9.
Proteins of the matrix metalloproteinase (MMP) family are involved in the breakdown of extracellular matrix in normal physiological processes, such as embryonic development, reproduction, and tissue remodeling, as well as in disease processes, such as arthritis and metastasis. Most MMP's are secreted as inactive proproteins which are activated when cleaved by extracellular proteinases. The enzyme encoded by this gene degrades type IV and V collagens. Studies in rhesus monkeys suggest that the enzyme is involved in IL-8-induced mobilization of hematopoietic progenitor cells from bone marrow, and murine studies suggest a role in tumor-associated tissue remodeling. [provided by RefSeq, Jul 2008].

| 应用 | 已检合格种属 | 预测种属 | 推荐稀释比例 |
|---|---|---|---|
| WB | Human, Rat | Mouse | 1:2000-20000 |
| IHC-P | Human, Mouse, Rat | 1:200-1000 | |
| IHC-F | Human, Mouse, Rat | 1:200-1000 | |
| IF | Human, Mouse, Rat | 1:200-1000 |
交叉反应: Human, Mouse, Rat
暂无相关产品
暂无标记数据
暂无同靶标产品
暂无相关文献
暂无常见问题